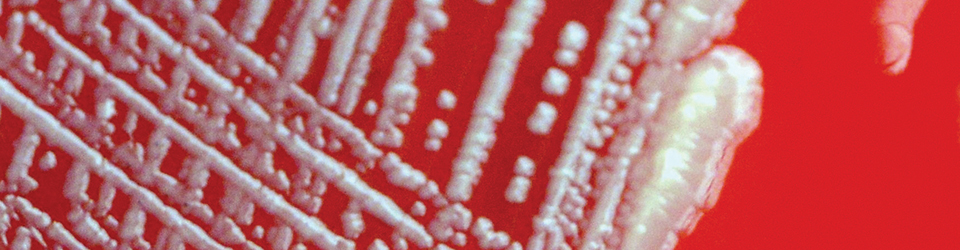
ws_ecoli_960.jpg ws_ecoli_960.jpg

Living Specimens
Observe and study the widest variety of species available for education
Our on-site living materials labs carry the widest selection of live specimen options, and are located from coast to coast - so they always arrive fresh, healthy and ready when you are! And if you have questions, we're always here to help from our science labs to yours.
Are you expecting a live materials shipment this week, but your school is closed due to inclement weather? Please notify Ward's Customer Service (1-800-962-2660) to adjust your ship date and ensure the health of your live materials upon delivery.
Ward's Science Perishable Materials Redemption








